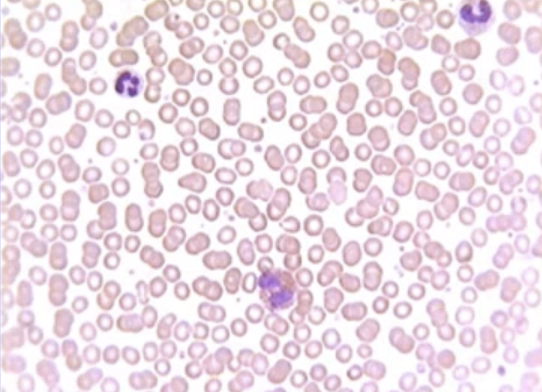
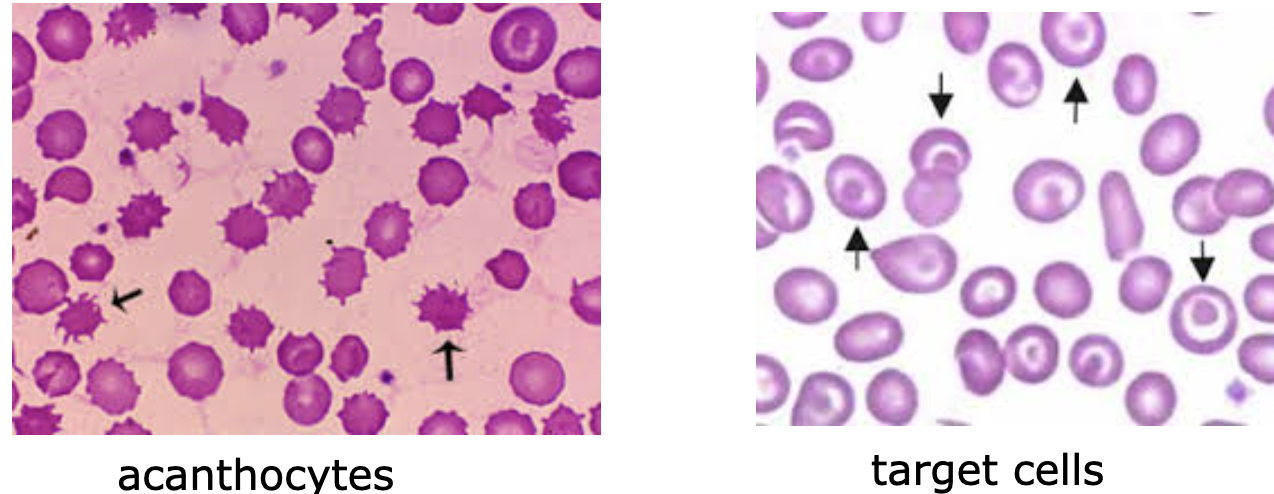
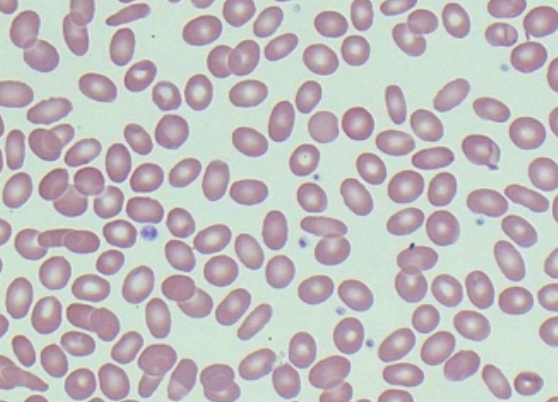

What does blood consist of?

Label what cells you can see on a normal blood film
Red cells = predominant. Purple looking cells= white cells. Red dots which appear much smaller= platelets
Describe and explain red blood cells
RBCs/erythrocytes are biconcave discs. No nucleus, mitochondria and ER.
Narrow in the centre to be able to deform & pass through 3 micron capillaries sin fragmentation.
Diameter = ~8 micro m. Thickness= ~2 micro m
What is the red blood cell membrane made of?
Red cell membrane consists of: proteins, lipids and carbs in a semi-permeable lipid bilayer. there is:
An outer hydrophilic portion composed of glycolipids, glycoproteins, and proteins.
A central hydrophobic layer with proteins, cholesterol, and phospholipids
An inner hydrophilic layer of mesh-like cytoskeletal proteins to support lipid bilayer.

The lipid component of the RBC membrane includes…
How are the lipid components arranged in the cell membrane?
…Phospholipids, Cholesterol, Sphingolipids
Phospholipids are distributed asymmetrically. there is free cholesterol between the bilayer to ⇡ membrane fluidity
The outer phospholipids are Phosphatidyl choline and Sphingomyelin. These are uncharged. Sphingolipids regulate the formation of lipid rafts for cell signalling
The inner phospholipids are charged ( Phosphatidyl ethanolamine and Phosphatidyl serine)
What are integral membrane proteins for RBCs?
Integral membrane proteins: Extend from outer surface and traverse entire lipid bilayer membrane to inner surface
2 major integral membrane proteins are glycophorins: A, B, and C, and band 3: anion transporter
Other integral proteins are: Na+/K+ ATPase, Aquaporin 1, surface receptors, e.g. TfR
What are peripheral proteins in the RBC membrane?
Peripheral proteins are imited to cytoplasmic surface of the membrane and forms the RBC cytoskeleton.
The cytoskeleton acts as tough framework to support the bilayer, it’s responsible for deformability & maintains biconcave shape.
Major peripheral proteins: Spectrin, Ankyrin, Protein 4.1 and Actin
Describe and explain spectrin
Spectrin is the most abundant peripheral protein. Composed of alpha & beta chains
V important in RBC membrane integrity bc it binds w other peripheral proteins to form the cytoskeletal network of microfilaments.
It controls biconcave shape and deformability of cell. If denatured RBC becomes spherical, loses flexibility
Explain ankyrin, protein 4.1 and actin in the rbc membrane
Ankyrin: primarily anchors lipid bilayer to membrane skeleton by interacting w spectrin and Band 3
Protein 4.1: may link the cytoskeleton to the membrane by associating w glycophorin. It also stabilises interaction of spectrin w actin
Actin:contracts/relaxes the membrane. Strong cohesion between bilayer and membrane skeleton maintains SA.
Explain the carbohydrates found in RBC membranes
They occur only on the external surface of cell.
The carbohydrate groups are attached to proteins and lipids by process called glycosylation.
Can contain 2-60 monosaccharide units, either branched or straight.
The carbohydrate gives a cell identity; the distinguishing factor for human blood types.
Which monosaccarides are found on the red cell membrane?

What are blood group antigens?
Blood group antigens on RBC membrane determine our blood group.
Many antigens are proteins: e.g. Rhesus, Duffy, Kidd. Others are carbohydrates; e.g. ABO. Others are combo of glycolipids and proteins.
What is the primary function of the RBC? How is it adapted to its function?
Primary function of RBC is transport of resp gases to and from the tissues.
Its deformability and elasticity allows passage through capillaries. They travel the microvascular system sin mechanical or shape damage, which facilitates gas exch.
The RBCM is tough yet highly flexible- Cytoskeletal proteins interact w the membrane lipid bilayer for strength and flexibility.
The biconcave shape provides optimum SA:V ratio for resp exchange
What does an increase in free plasma cholesterol signify?
What does increased cholesterol lead to? Draw these
Membrane cholesterol exists in eqm w plasma cholesterol. So, ⇡ in free plasma cholesterol causes accumulation of cholesterol in the RBCM
RBCs with increased cholesterol appear distorted and form acanthocytes.
Increase in cholesterol and phospholipid is a cause of target cells. These are RBCs that look like a target.
Target cells appear when the surface of the red cell ⇡ disproportionately to its volume. Can be due to a decrease in Hb or an increase in cell membrane.
Explain Hereditary Spherocytosis
Caused by mutations in membrane protein genes that allow for the erythrocytes to change shape.
Eg you can have deficiency or abnormalities for: Ankyrin, A or B spectrin, Band 3 protein, Protein 4.2.
Erythrocytes get sphere-shaped (spherocytosis), not biconcave. Dysfunctional membrane proteins limit the cell’s flexiblity to travel from arteries to capillaries. Shape change also makes the RBCs more prone to rupture.

Hereditary Elliptocytosis?
Genetic disorder which causes anaemia symptoms, cells become more elliptical. Can be caused by:
A or B spectrin mutation – defective spectrin dimer
A or B spectrin mutation – defective spectrin-ankyrin association
Protein 4.1 deficiency or abnormalities
Explain the following terms: Anisocytosis, poikilocytosis, macrocytes, microcytes.
Anisocytosis= RBCs of varying sizes on your blood smear.
Poikilocytosis= RBCs of varying shapes on your blood smear.
Macrocytes are larger than normal red blood cells, microcytes are smaller than normal red blood cells.
Causes: anemias, hereditary spherocytosis/elliptocytosis, thalassemia etc
What features allow RBC to withstand life without structural deterioration?
Geometry of cell; SA:V ratio facilitates deformation whilst maintaining constant SA.
Membrane deformability: spectrins undergo reversible change in conformation: some uncoiled and extend, others compress and fold.
Cytoplasmic viscosity determined by MCHC (mean cell Hb content). As MCHC rises, viscosity rises exponentially.
Explain haemoglobin’s structure.
Haemoglobin (Hb) is a globular haemoprotein. Haemoproteins are group of specialized proteins that contain haem as a tightly bound prosthetic group.
Haem is a complex of protoporphyrin IX and ferrous (Fe2+). Fe2+ is bonded to the 4 nitrogen of a porphyrin ring.
Globin: 4 polypep subunits, 2 α-globin chains and 2 β-globin chains

Haemoglobinopathies?
Haemoglobinopathies are a group of recessively inherited genetic conditions affecting Hb
There is 2 categories: Thalassaemias and Sickle Cell Disease
Describe and explain the red cell enzymes.
2 main enzymes: G-6-P dehydrogenase (G-6-PD) and Pyruvate Kinase (PK). These support pentose phosphate and Glycolysis pathways
The pathways provide energy required for: Maintenance of cation pumps, maintenance of RBC integrity and deformability, maintenance of Hb in reduced state
Methaemoglobin reductase maintains iron in ferrous state
Describe neutrophils
They are bigger than RBCs and are polymorphonuclear, meaning have an irregular, multi lobed nucleus.
It is a granulocyte, so contains prominent cytoplasmic granules. They phagocytose and kill bacteria and fungi.
Are the main mediators of innate immunity.

What can granulocytes refer to?
Granulocyte describes neutrophils but it can also refer to:
Eosinophils, where the granules stain red w eosin. 1-4% of wbcs. Used in allergic reactions and kills parasites
Basinophils, where granules stain blue/purple w basic dyes. <0.5%. Involved in defence against bacteria, kill parasites, involved in inflammation

What are mononuclear cells?
Mononuclear cells lack granules, with large regular nuclei. Hay:
monocytes involved in phagocytosis, and lymphocytes involved in antibody production, generally for viruses.